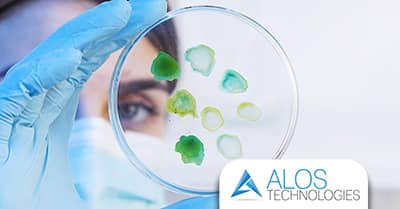
Il ruolo strategico del trattamento anti-Legionella

Il Blog di Alos Technologies
La sezione riporta le novità nei servizi e nelle attività di progettazione, di produzione e di commercializzazione dei dispositivi medici; di apparecchiature per i monitoraggi dei Gas e dell'ambiente. Un canale sempre puntato sulle più recenti scoperte dei sistemi nel settore della sanità, per una migliore informazione e conoscenza di tutti.

- Dettagli
- Scritto da Roberto
Un servizio full-service per le sale operatorie consente di garantire massima sicurezza, efficienza operativa e conformità normativa, grazie a una gestione integrata di tutte le fasi: dalla progettazione alla realizzazione fino alla manutenzione. Affidarsi a un unico partner specializzato permette di semplificare i processi, ridurre i rischi e ottimizzare tempi e costi. Alos Technologies, società operante dal 2009 nel settore sanitario sia pubblico che privato, rappresenta un punto di riferimento per l’allestimento sale operatorie, offrendo soluzioni “chiavi in mano” e un servizio full-service.

- Dettagli
- Scritto da Roberto
Garantire la sicurezza in una sala di crioconservazione significa adottare sistemi integrati di controllo, monitoraggio continuo e progettazione impiantistica avanzata, in grado di proteggere sia i campioni biologici sia gli operatori.
La crioconservazione rappresenta un processo delicato, che richiede il mantenimento costante di condizioni estreme e controllate. Per questo motivo, la gestione degli impianti di crioconservazione deve rispettare standard elevati di sicurezza, affidabilità e continuità operativa. In questo contesto, Alos Technologies si distingue come partner specializzato nell’allestimento di sale di crioconservazione, offrendo soluzioni complete.

- Dettagli
- Scritto da Roberto
La sanificazione ambientale è fondamentale per assicurare la sicurezza e la qualità dell’aria all’interno di ospedali, laboratori, studi medici e strutture pubbliche o private. Un ambiente correttamente sanificato riduce la presenza di microrganismi patogeni, virus, batteri e spore, proteggendo pazienti, operatori e visitatori. Alos Technologies propone un servizio di sanificazione ambientale completo e innovativo, in grado di integrare procedure tradizionali e tecnologie avanzate per ottenere risultati certificati e duraturi. Scopri di più in questo articolo.
- Dettagli
- Scritto da Roberto
La prevenzione della legionellosi si basa su una gestione attenta e continuativa delle reti idriche e degli impianti che possono favorire la proliferazione del batterio Legionella. Il trattamento anti-Legionella rappresenta quindi uno strumento strategico per ridurre il rischio di contaminazione dell’acqua e garantire ambienti sicuri, soprattutto in strutture sanitarie, ospedali, cliniche e RSA. Alos Technologies, società che opera dal 2009 nel settore della sanità pubblica e privata, offre servizi specializzati di analisi, monitoraggio e trattamento anti-Legionella, supportando le strutture nella gestione completa del rischio biologico e nella conformità alle normative vigenti.

- Dettagli
- Scritto da Roberto
La nutrizione artificiale domiciliare è un trattamento sanitario che consente di fornire al paziente i nutrienti necessari quando non è possibile alimentarsi in modo autonomo e sufficiente per via naturale. Può avvenire per via enterale (attraverso sondino o PEG) o parenterale (per via endovenosa) e rappresenta una soluzione fondamentale per garantire continuità terapeutica, qualità di vita e sicurezza clinica direttamente a casa. In questo ambito, realtà specializzate come Alos Technologies svolgono un ruolo centrale, offrendo un servizio di assistenza tecnica domiciliare completo, strutturato e integrato con il piano di cura del paziente. Scopri di più nell’articolo.

- Dettagli
- Scritto da Roberto
La criobiologia e la crioconservazione richiedono competenze altamente specialistiche, impianti tecnologicamente avanzati e un sistema di controllo continuo dei parametri critici. I servizi integrati di Alos Technologies rispondono proprio a questa esigenza: progettazione, realizzazione, monitoraggio e manutenzione di ambienti e impianti dedicati alla conservazione a bassissime temperature, con un approccio full-service che garantisce sicurezza, continuità operativa e conformità normativa.
